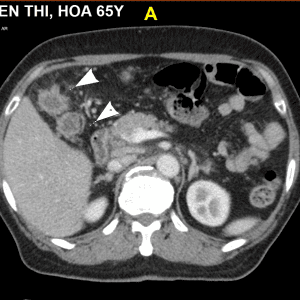
Di căn phúc mạc

TIÊU HOÁ
Hiển thị 721–740 của 1445 kết quảĐã sắp xếp theo mới nhất
-

Thoát vị hoành
Lượt xem: 154» 14-04-2020 -

Chấn thương mạc treo ruột
Lượt xem: 201» 10-04-2020 -

Chấn thương gan
Lượt xem: 236» 08-04-2020 -

Di căn phúc mạc
Lượt xem: 57» 08-04-2020 -

Thiếu máu mạc treo ruột
Lượt xem: 228» 05-04-2020 -

Thoát vị nghẹt
Lượt xem: 307» 03-04-2020 -

HCC
Lượt xem: 228» 31-03-2020 -

Thoát vị bẹn
Lượt xem: 1042» 27-03-2020 -

Loét thủng bít
Lượt xem: 812» 27-03-2020 -

Viêm tụy hoại tử
Lượt xem: 217» 22-03-2020 -

Chấn thương mạc treo – ruột
Lượt xem: 226» 22-03-2020 -

Viêm ruột thừa
Lượt xem: 201» 17-03-2020 -

U cơ tuyến túi mật
Lượt xem: 338» 06-03-2020 -

Chấn thương lách
Lượt xem: 215» 03-03-2020 -

Vỡ túi mật
Lượt xem: 182» 03-03-2020 -

Thủng túi thừa đại tràng
Lượt xem: 274» 03-03-2020 -

Chấn thương mạc treo ruột
Lượt xem: 213» 03-03-2020 -

Vỡ túi mật
Lượt xem: 220» 03-03-2020 -

Chảy máu túi mật
Lượt xem: 225» 03-03-2020 -

Nhồi máu mạc nối
Lượt xem: 213» 17-02-2020